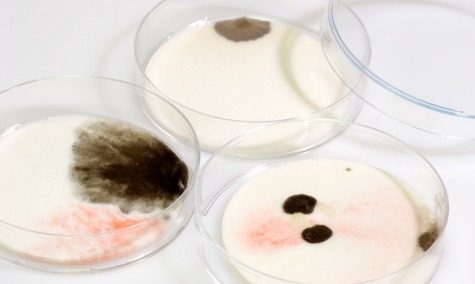

Tydligare regler för SVA:s prislista
I somras ändrade regeringen instruktionen för hur SVA får bedriva uppdragsverksamhet, exempelvis labbtester. Privata aktörer har länge anklagat SVA för prisdumpning. De nya reglerna ska göra det tydligt vad SVA får göra.
Det privata veterinärmedicinska laboratoriet Vidilab menar att SVA under lång tid har dumpat priserna, något som SVA förnekat. Det skriver tidningen Entreprenör.
Men i somras beslutade regeringen för att förtydliga instruktionen för SVA:s uppdragsverksamhet, alltså tjänster som även utförs av privata företag, som provanalys.
– I formell mening räcker det med konkurrenslagstiftningens skrivning, men detta bidrar till ökad tydlighet, säger Tobias Olsson på Djur- och livsmedelsenheten, Landsbygdsdepartementet till Entreprenör.
Så här står det i den nya instruktionen:
”Den uppdragsverksamhet som utförs vid myndigheten ska ske i enlighet med myndighetens uppdrag och ansvar. Finns det privata utförare som tillhandahåller samma varor och tjänster, ska uppdragsverksamheten bedrivas i begränsad omfattning för att inte hämma förutsättningarna för en effektiv konkurrens på marknaden, om det inte finns särskilda skäl för något annat. Behovet av att utföra uppdragsverksamhet ska löpande analyseras och dokumenteras.”
Detta tolkas av privata laboratorier som att regeringen nu förbjuder SVA att hålla lägre priser än sina privata konkurrenter.
På SVA menar generaldirektör Jens Mattsson att de nya instruktionerna inte innebär någon skärpning:
– Jag ser det som positiva förändringar. Det klargör och förtydligar, vilket är bra för verksamheten, säger Jens Mattson till Entreprenör.
(Källa: Entreprenör)














